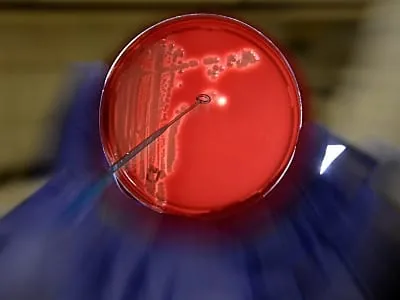
EHEC-Erreger könnte aus Biogasanlagen kommen

Verbraucherschutzministerium spricht von "purer Spekulation" EHEC-Erreger könnte aus Biogasanlagen kommen
Bei der Suche nach der Herkunft des gefährlichen EHEC-Erregers sind jetzt Biogasanlagen ins Blickfeld gerückt: Veterinär- und Labormediziner halten es für möglich, dass der Keim dort herkommt, wie die "Welt am Sonntag" und das ARD-Magazin "Report Mainz" berichteten. Die Biogasbranche wies dies zurück. Auch das Bundesverbraucherschutzministerium sprach auf dapd-Anfrage von "purer Spekulation".
› mehr